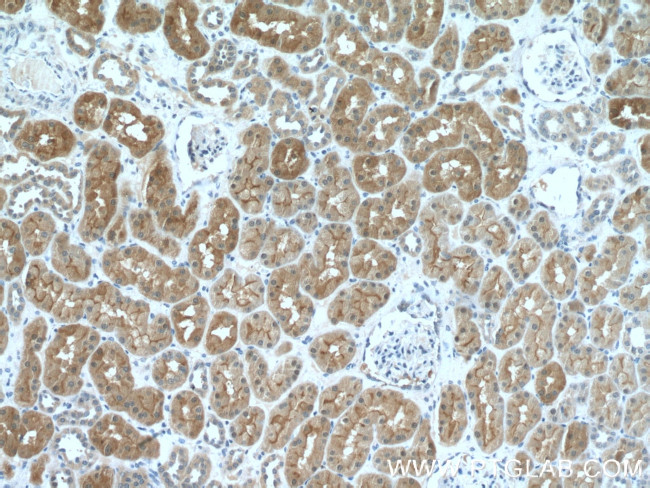
MIOX Antibody in Immunohistochemistry (Paraffin) (IHC (P))

Search
Proteintech
MIOX Polyclonal Antibody
{{$productOrderCtrl.translations['antibody.pdp.commerceCard.promotion.promotions']}}
{{$productOrderCtrl.translations['antibody.pdp.commerceCard.promotion.viewpromo']}}
{{$productOrderCtrl.translations['antibody.pdp.commerceCard.promotion.promocode']}}: {{promo.promoCode}} {{promo.promoTitle}} {{promo.promoDescription}}. {{$productOrderCtrl.translations['antibody.pdp.commerceCard.promotion.learnmore']}}





Please note: We are reviewing Western blot images included in the antibody testing data in our catalog, including those provided by third parties. Unless expressly labeled or annotated as “raw-unedited”, Western blot images included in the antibody testing data in our catalog may have been edited, optimized or otherwise adjusted for presentation.
产品信息
17623-1-AP
种属反应
宿主/亚型
分类
类型
抗原
偶联物
形式
浓度
规格
纯化类型
保存液
内含物
保存条件
运输条件
产品详细信息
Immunogen sequence: MKVTVGPDP SLVYRPDVDP EVAKDKASFR NYTSGPLLDR VFTTYKLMHT HQTVDFVRSK HAQFGGFSYK KMTVMEAVDL LDGLVDESDP DVDFPNSFHA FQTAEGIRKA HPDKDWFHLV GLLHDLGKVL ALFGEPQWAV VGDTFPVGCR PQASVVFCDS TFQDNPDLQD PRYSTELGMY QPHCGLDRVL MSWGHDEYMY QVMKFNKFSL PPEAFYMIRF HSFYPWHTGR DYQQLCSQQD LAMLPWVREF NKFDLYTKCP DLPDVDKLRP YYQGLIDKYC PGILSW (1-285 aa encoded by B C073848)
靶标信息
MIOX (Myo-Inositol Oxygenase) is a Protein Coding gene. Among its related pathways are superpathway of inositol phosphate compounds and Porphyrin and chlorophyll metabolism. Gene Ontology (GO) annotations related to this gene include iron ion binding and oxidoreductase activity, acting on NAD(P)H.
仅用于科研。不用于诊断过程。未经明确授权不得转售。
篇参考文献 (0)
生物信息学
蛋白别名: aldehyde reductase (aldose reductase) like 6; aldehyde reductase (aldose reductase)-like 6; aldehyde reductase 6, renal; Aldehyde reductase-like 6; Inositol oxygenase; Kidney-specific protein 32; MI oxygenase; Myo-inositol oxygenase; renal-specific oxido-reducatse; renal-specific oxido-reductase; Renal-specific oxidoreductase
基因别名: 0610009I10Rik; AI314022; ALDRL6; C85427; KSP32; MIOX; RSOR
UniProt ID: (Rat) Q9QXN4, (Mouse) Q9QXN5
Entrez Gene ID: (Rat) 252899, (Mouse) 56727